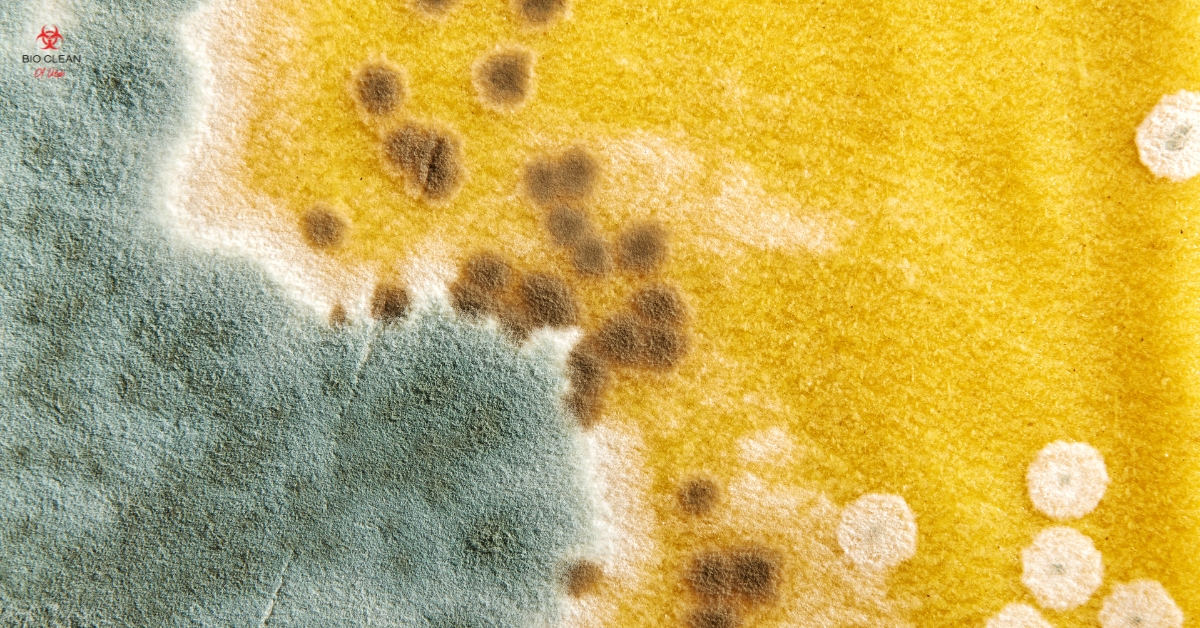
Black Mold VS Mildew in Utah Homes Comparison image of black mold and mildew in a Utah home

How Can a Professional Restoration Service Help After a Flood?
Experiencing a flood can be stressful and challenging for Utah homeowners. The water damage can lead to severe structural issues, mold growth, and even personal loss. That’s where professional restoration services come in. These experts can help turn back the clock, restoring your home to its former condition and helping you rebound from the disaster.…
Details